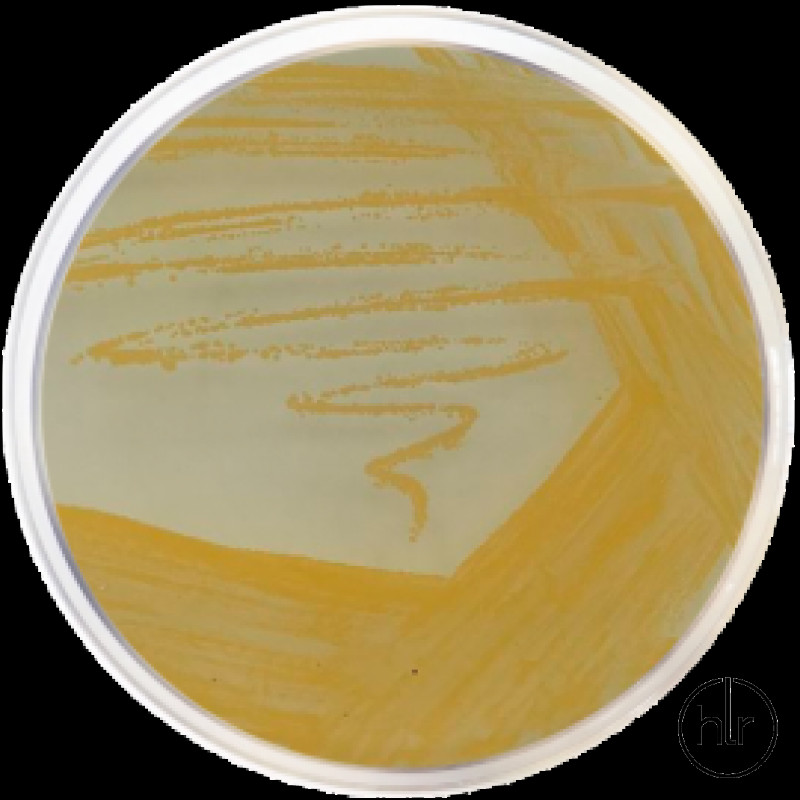
Агар для стафилококков Nº 110 Conda  500 г

Агар для стафилококков Nº 110 Conda 500 г
Агар для стафилококков №110 — селективная питательная среда, используемая для выделения патогенных стафилококков из клинических и неклинических образцов на основе ферментации маннита, образования пигмента и желатиназной активности.
Стафилококки являются причиной многих случаев пневмонии, менингита, фурункулёза, уретрита, вагинита и др. Среда также применяется для выделения стафилококков, контаминирующих различные пищевые продукты и вызывающих пищевые отравления.
Казеиновый пептон обеспечивает азот, витамины, минералы и аминокислоты, необходимые для роста. Дрожжевой экстракт является источником витаминов, особенно группы B. Лактоза и D-маннит — ферментируемые углеводы, служащие источниками энергии. Двухзамещённый фосфат калия выполняет роль буфера. Хлорид натрия обеспечивает электролиты для транспорта и осмотического баланса и в высокой концентрации подавляет рост большинства бактерий, кроме стафилококков. Желатин включён для определения его разжижения. Бактериологический агар служит в качестве загустителя.
Патогенные стафилококки (коагулазоположительные) устойчивы к высокой концентрации NaCl и образуют золотисто-жёлтые пигментированные колонии.
Ферментацию маннита с образованием кислоты выявляют добавлением нескольких капель бромтимолового синего на поверхность агара и обнаружением жёлтого ореола вокруг колоний.
Стафилококки разжижают желатин, образуя зоны просветления вокруг колоний. На чашку можно добавить 5 мл насыщенного раствора сульфата аммония или несколько капель 20% сульфосалициловой кислоты и инкубировать 12 минут для наблюдения гидролиза желатина (реакция Стоуна).
Состав (г/л)
Бактериологический агар — 15
Казеиновый пептон — 10
Двухзамещённый фосфат калия — 5
D-маннит — 10
Желатин — 30
Лактоза — 2
Хлорид натрия — 75
Дрожжевой экстракт — 2,5
Инструкция по приготовлению
149,5 г среды суспендировать в 1 литре дистиллированной воды. Тщательно перемешать и растворить при нагревании с частым перемешиванием. Кипятить в течение 1 минуты до полного растворения. Стерилизовать в автоклаве при 121 °C в течение 15 минут. Охладить до 45–50 °C, хорошо перемешать и разлить по чашкам Петри.